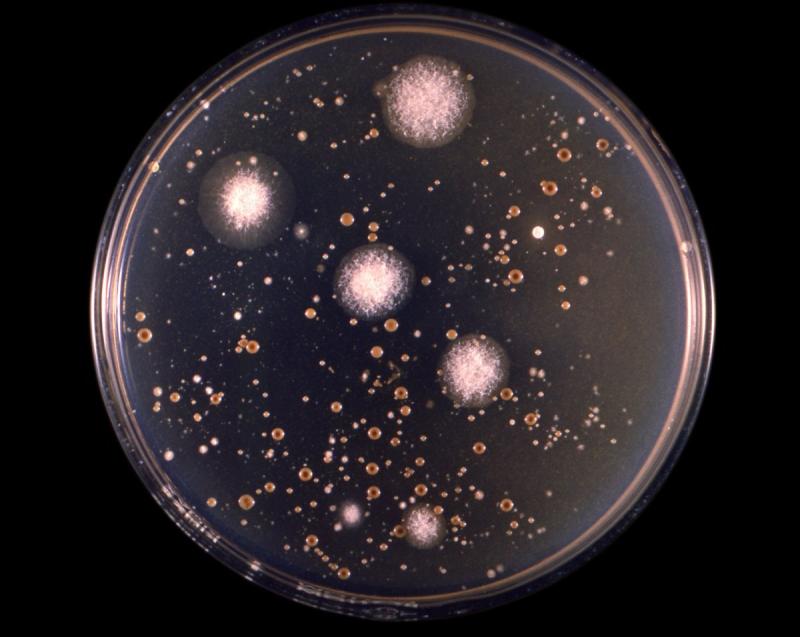

Press release
Global Cryptococcosis Treatment Market Size By Type, By Application, By Geographic Scope And Forecast 2032
Cryptococcosis Treatment Market Size And ForecastCryptococcosis Treatment Market size was valued at USD 4.2 Billion in 2018 and is projected to reach USD 6.6 Billion by 2026, growing at a CAGR of 4.4% from 2023 to 2032.
The market development of the Cryptococcosis Treatment Market is being driven by factors such as the rising prevalence of fatal fungal infections, cryptococcosis infections, and the accessibility of generic and over-the-counter (OTC) medications. The market is comprehensively evaluated in the study on the global cryptococcosis treatment market. The report provides a thorough analysis of the market's major segments, trends, drivers, restraints, competitive environment, and other important elements.
Global Cryptococcosis Treatment Market Definition
A chronic fungal illness in humans called cryptococcosis, also known as European blastomycosis or tollosis, is brought on by Cryptococcocis neoformans and Cryptococcocis gattii. Pigeon droppings frequently contain fungi, which can also be found in soil and dust. Window frames and other popular places for nesting also contain a lot of fungi. Inhaling fungus spores from the air results in human illnesses. Worldwide, cryptococcosis is a problem. For those who have the human immunodeficiency virus (HIV), it is the main cause of mortality, particularly in sub-Saharan Africa.
Cryptococcosis is a fungal infection that is caused by the Cryptococcus fungus. The infection is commonly found in people with weakened immune systems, such as those living with HIV/AIDS, and can lead to serious complications such as meningitis and pneumonia. The global cryptococcosis treatment market is expected to witness significant growth in the coming years, driven by the increasing prevalence of HIV/AIDS and other immunosuppressive conditions.
A chronic fungal illness in humans called cryptococcosis, also known as European blastomycosis or tollosis, is brought on by Cryptococcocis neoformans and Cryptococcocis gattii. Pigeon droppings frequently contain fungi, which can also be found in soil and dust. Window frames and other popular places for nesting also contain a lot of fungi. Inhaling fungus spores from the air results in human illnesses. Worldwide, cryptococcosis is a problem. For those who have the human immunodeficiency virus (HIV), it is the main cause of mortality, particularly in sub-Saharan Africa.
Global Cryptococcosis Treatment Market Overview
Malaise, a dry cough, and a temperature are all signs of cryptococcosis. Disseminated cryptococcosis, a more serious illness, accounts for one-tenth of all reported infections. In such circumstances, the fungus has the potential to move from the lungs to the brain and cause meningitis. Headache, blurred vision, confusion, lethargy, or personality changes are the primary signs and symptoms of meningitis. Additionally, lesions caused by Cryptococcus can affect the skin, bones, and internal systems. Immune compromised patients have a very high chance of developing cryptococcosis.
Additionally, increasing consumer awareness in both developed and developing nations contributes to market development. However, limited testing and diagnostic options due to the higher mortality rate among patients with cryptococcosis, patients' biassed clinical awareness, and less experienced technicians are impeding the development of the market for cryptococcosis treatments. Opportunities for the market growth of the cryptococcosis treatment market include expanding clinical trial ecosystems, increased government initiatives, and increased research and development in the creation of pharmaceuticals.
This report examines all the key factors influencing growth of global Cryptococcosis Treatment market, including demand-supply scenario, pricing structure, profit margins, production and value chain / ecosystem analysis. Regional assessment of global Cryptococcosis Treatment market unlocks a plethora of untapped opportunities in regional and domestic market places. Detailed company profiling enables users to evaluate company shares analysis, emerging product lines, scope of NPD in new markets, pricing strategies, innovation possibilities and much more.
Click Here To Access The Free Sample Report @ https://analyticsmarketresearch.com/sample-request/cryptococcosis-treatment-market/17693/
Market Segmentations:
Global Cryptococcosis Treatment Market: Major Players
Sigmapharm Laboratories
Janssen Biotech
Novartis AG
Pfizer
Johnson & Johnson
Abbott Laboratories
Valeant Pharmaceuticals
Glenmark Pharmaceuticals
Bristol-Myers Squibb
Global Cryptococcosis Treatment Market: By Types
Amphotericin B
Flucytosine
Fluconazole
Global Cryptococcosis Treatment Market: By Applications
Hospital Pharmacies
Retail Pharmacies
Drug Store
Other
Global Cryptococcosis Treatment Market: Regional Analysis
All the regional segmentation has been studied based on recent and future trends, and the market is forecasted throughout the prediction period. The countries covered in the regional analysis of the Global Cryptococcosis Treatment market report are U.S., Canada, and Mexico in North America, Germany, France, U.K., Russia, Italy, Spain, Turkey, Netherlands, Switzerland, Belgium, and Rest of Europe in Europe, Singapore, Malaysia, Australia, Thailand, Indonesia, Philippines, China, Japan, India, South Korea, Rest of Asia-Pacific (APAC) in the Asia-Pacific (APAC), Saudi Arabia, U.A.E, South Africa, Egypt, Israel, Rest of Middle East and Africa (MEA) as a part of Middle East and Africa (MEA), and Argentina, Brazil, and Rest of South America as part of South America.
Purchase This Premium Report Now @ https://analyticsmarketresearch.com/purchase/cryptococcosis-treatment-market/17693/?license=single
An Overview of the Impact of COVID-19 on Market: The emergence of COVID-19 has brought the world to a standstill. We understand that this health crisis has brought an unprecedented impact on businesses across industries. However, this too shall pass. Rising support from governments and several companies can help in the fight against this highly contagious disease. There are some industries that are struggling and some are thriving. Overall, almost every sector is anticipated to be impacted by the pandemic. We are taking continuous efforts to help your business sustain and grow during COVID-19 pandemics. Based on our experience and expertise, we will offer you an impact analysis of coronavirus outbreak across industries to help you prepare for the future.
In conclusion, the global cryptococcosis treatment market is expected to witness significant growth in the coming years, driven by the increasing prevalence of HIV/AIDS and other immunosuppressive conditions. Market players can capitalize on this growth by developing new treatment options and expanding their presence in emerging markets. However, the high cost of treatment and the lack of awareness and diagnostic tools in low- and middle-income countries remain significant challenges for the market.
Read Full Research Report @ https://analyticsmarketresearch.com/reports/cryptococcosis-treatment-market/17693/
Reasons to Get this Report:
The analysis covers global market and its advancements across different industry verticals as well as regions. It targets estimating the current market size and growth potential of the global market across sections such as also application and representatives.
In an insight outlook, this research report has dedicated to several quantities of analysis - industry research (global industry trends) and global market share analysis of high players, along with company profiles, and which collectively include about the fundamental opinions regarding the market landscape; emerging and high-growth sections of global market; high-growth regions; and market drivers, restraints, and also market chances.
Additionally, the analysis also has a comprehensive review of the crucial players on the global market together side their company profiles, SWOT analysis, latest advancements, and business plans.
Contact US:
Analytics Market Research
99 WALL STREET, #2124 NEW YORK, NY 10005
Phone: +1(650)-666-4592
Email: sales@analyticsmarketresearch.com
About US:
Analytics Market Research is an established market analytics and research firm with a domain experience sprawling across different industries. We have been working on multi-county market studies right from our inception. Over the time, from our existence, we have gained laurels for our deep rooted market studies and insightful analysis of different markets.
Our strategic market analysis and capability to comprehend deep cultural, conceptual and social aspects of various tangled markets has helped us make a mark for ourselves in the industry. Analytics Market Research is a frontrunner in helping numerous companies; both regional and international to successfully achieve their business goals based on our in-depth market analysis. Moreover, we are also capable of devising market strategies that ensure guaranteed customer bases for our clients.
This release was published on openPR.
Permanent link to this press release:
Copy
Please set a link in the press area of your homepage to this press release on openPR. openPR disclaims liability for any content contained in this release.
You can edit or delete your press release Global Cryptococcosis Treatment Market Size By Type, By Application, By Geographic Scope And Forecast 2032 here
News-ID: 2978497 • Views: …
More Releases from Analytics Market Research
Global Texture Paint Market Rising Trends, Technology Research and Advancement O …
The Global Texture Paint Market size was valued at USD 12,400 million in 2022 and is projected to reach USD 16,700 million by 2033, growing at a CAGR of 4.5% during the forecast period.
The texture paint market refers to the industry involved in the production, distribution, and sale of texture paints. Texture paints are specialized coatings used to add texture and visual interest to surfaces, such as walls, ceilings, furniture,…
Guarding the Global Flow: Exploring the Growth Potential and Security Innovation …
The global Supply Chain Security Market size was valued at USD 2.56 billion in 2022, and is projected to reach USD 3.57 billion by 2032 at a CAGR of 11.5% from 2023 to 2032.
The supply chain security market refers to the set of solutions and services aimed at securing the flow of goods, services, and information across the global supply chain. The primary objective of supply chain security is to…
Clouding the Future: Unveiling the Global Public Cloud Market's Transformation a …
The global public cloud market was estimated at USD 211.5 billion in 2019 and is expected to grow at a compound annual growth rate (CAGR) of 14.6% from 2023 to 2032. Rapid progress of digital transformation in the industry, prevalence of internet and mobile devices, and increasing consumption of big data are the major drivers of market growth.
Developing next-generation industrial solutions is leveraging the cloud and requires a platform that…
Revolutionizing Education: Exploring the Global Learning Management System Marke …
The global Learning Management System Market size was valued at USD 27.56 billion in 2022, and is projected to reach USD 62.57 billion by 2032 at a CAGR of 18.5% from 2023 to 2032.
A Learning Management System (LMS) is a software application designed to manage and deliver educational and training courses, resources, and assessments to learners. It is used by educational institutions, businesses, and organizations to create and deliver courses,…
More Releases for Cryptococcosis
Cryptococcosis Market Growing Demand for Effective Diagnostics and Treatments
Sub-Headline: The global cryptococcosis market is expected to grow at a significant pace due to increased research, advancements in diagnostic tools, and expanding treatment options.
Introduction:
The global cryptococcosis market is poised for substantial growth due to rising awareness about the disease, enhanced diagnostic techniques, and the growing need for effective antifungal treatments. Cryptococcosis, caused by the Cryptococcus fungus, is a serious fungal infection that primarily affects immunocompromised individuals, such as those…
Cryptococcosis Market Future Prediction Report By 2031
Cryptococcosis Market business research report assesses the current as well as upcoming performance of the market, also brand-new trends in the market. It provides product overview and highlights of product and application segments of the market including price, revenue, sales, sales growth rate, and market share by product. The market statistics within the report is displayed in a statistical format to offer a better understanding upon the market dynamics.
Download…
Cryptococcosis Market Opportunities, Business Forecast To 2029
According to Precision Business Insights (PBI), latest report cryptococcosis market was valued at USD 5,273.5 million in 2022, growing at an 4.5% CAGR from 2023 to 2029. The market for cryptococcosis is driven by the prevalence of low immunity among a large portion of the population brought on by smoking, alcohol use, poor nutrition, rising disease prevalence, and stress, which makes it easier to contract the disease. Furthermore, an increase…
Cryptococcosis Market to Develop Rapidly by 2031, TMR Study
The global cryptococcosis market is estimated to attain a valuation of US$ 4.9 Bn by the end of 2027, states a study by Transparency Market Research (TMR). Besides, the report notes that the market is prognosticated to expand at a CAGR of 4.3% during the forecast period, 2019 to 2027.
The key objective of the TMR report is to offer a complete assessment of the global market including major leading stakeholders…
Cryptococcosis Market Growth Opportunities from 2022 - 2031, TMR Study
The global cryptococcosis market is estimated to attain a valuation of US$ 4.9 Bn by the end of 2027, states a study by Transparency Market Research (TMR). Besides, the report notes that the market is prognosticated to expand at a CAGR of 4.3% during the forecast period, 2019 to 2027.
The key objective of the TMR report is to offer a complete assessment of the global market including major leading stakeholders…
Lupin Limited launched Ancobon Capsules’ for cryptococcosis treatment market
The growing prevalence of cryptococcus disease is escalating the growth of the cryptococcosis treatment market. The Centers for Disease Control and Prevention (CDC) states that around 1 million cryptococcosis cases arise throughout the globe, and it is anticipated that annually, the number of deaths associated with cryptococcosis is around 650,000. Most of the cases are reported among patients with complex HIV disease. Moreover, rising count of people being contaminated by…